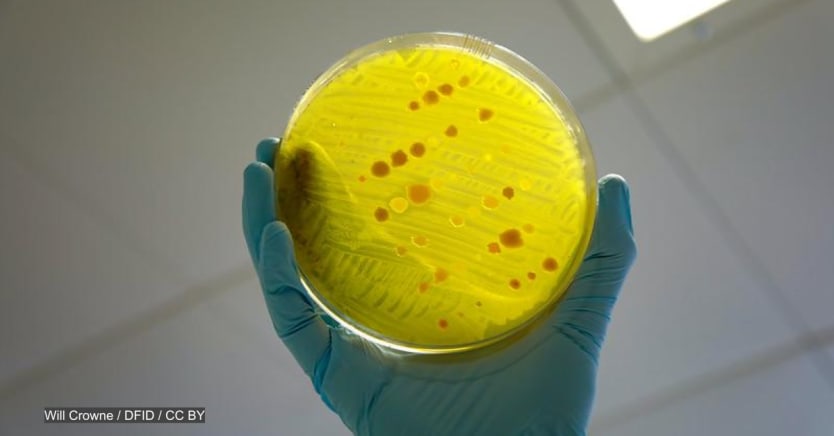

A new fund focusing on antimicrobial resistance, or AMR, is trying to inject life into a weak clinical pipeline of new antibiotics that treat drug-resistant bacteria. But because of the lackluster market for these drugs, the fund’s CEO says its efforts won’t be enough to solve the problem.
“I think we're [going to] have an impact at the AMR Action Fund, but despite it being a billion-dollar fund, this is really a stopgap. This is not a solution to the problem,” Henry Skinner, CEO at AMR Action Fund, said during a press briefing on Thursday.
“Hopefully this buys us time to advance some programs, bring a few drugs to patients. But ultimately, we need a robust market that does this on a steady state basis for many, many, many decades to come,” he added.
The AMR Action Fund is an initiative that aims to invest $1 billion to bring two to four new antibiotics to patients by 2030, addressing drug-resistant bacteria causing life-threatening infections. It’s a public-private partnership launched in July 2020 between banks, pharmaceutical companies, and charitable foundations, and is meant to rebuild what it calls a “collapsing antibiotic pipeline.”
The World Health Organization’s latest “Antibacterial Pipeline Report,” published Thursday, shows only 43 antibiotics in clinical development. Of these, 26 are targeted at WHO’s priority pathogens, including two for the multidrug resistant Gram-negative bacteria, which causes infections such as pneumonia and meningitis.
“The pipeline is insufficient to actually counter the rising resistance against these priority bacteria,” said Peter Beyer, who leads a team on antimicrobial resistance at the World Health Organization.
The pipeline for new antibiotics pales in comparison to other research areas, such as cancer, for which thousands of treatments are currently in clinical development. But Beyer said revenue drives investments, noting that a new cancer treatment generates more revenue than a single antibiotic.
More on antimicrobial resistance:
► Opinion: Why tackling the silent crisis of drug-resistant infections matters more than ever
► Opinion: We need to improve AMR surveillance systems, now more than ever
► Opinion: How to oppose the menace of antimicrobial resistance
The market for the antibiotics in development is already anticipated to be small, since each will be targeting specific resistant bacteria. WHO also advises that these antibiotics should only be reserved for patients suffering from a resistant bacterial infection. That makes it hard for companies to generate revenue, and also difficult to sustain a product in the market, Beyer said.
To get a drug through clinical trials and have it registered already costs over $250 million, not including the cost of capital and the cost of failure, said Beyer.
But this lack of investment is costing lives. The European Centre for Disease Prevention and Control estimates 33,000 deaths each year in the EU and European Economic Area are attributable to infections caused by antibiotic-resistant bacteria, according to a 2018 study. In the United States, over 2.8 million people suffer from infections caused by antibiotic-resistant bacteria each year, leading to more than 35,000 deaths, according to a 2019 CDC report.
It’s unclear how big the burden of antimicrobial resistance is in low- and middle-income countries given the scarcity in data, but antimicrobial resistance is “most severe in resource-constrained settings,” according to a WHO news release. Drug-resistant diseases could cause the deaths worldwide of 10 million people each year by 2050, according to a 2019 report by the ad hoc U.N. Interagency Coordination Group on Antimicrobial Resistance.
Initiatives such as the AMR Action Fund, the Global Antibiotic R&D Partnership and CARB-X are helping fill gaps in antibiotic R&D. But, Beyer said, countries also need to rethink the way they reimburse and procure these antibiotics as incentives for private investment to continue and ensure products don’t disappear from the market.









